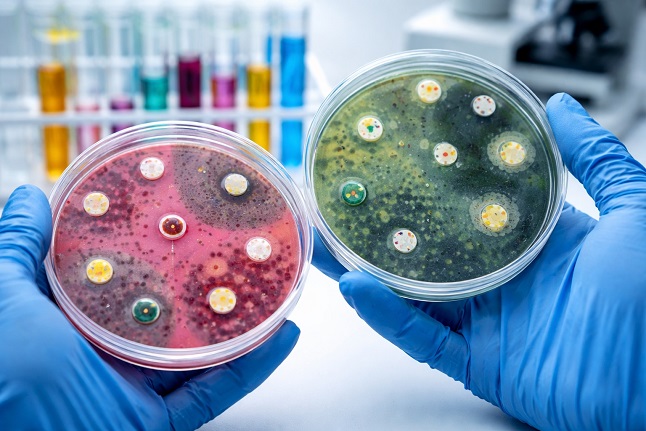

Nikhil Prasad Fact checked by:Thailand Medical News Team Apr 12, 2026 1 month, 4 weeks, 4 hours, 38 minutes ago
Medical News: A new wave of antibiotic-resistant bacteria is quietly emerging in France, raising fresh concerns among scientists and public health experts. Researchers have identified several newly evolved variants of a dangerous enzyme that allows bacteria to resist some of the most powerful antibiotics available today. These findings highlight a growing and complex threat that could make infections harder to treat in the years ahead.
 New antibiotic-resistant bacterial variants are emerging and spreading across France, raising global health concerns
What Are These New Variants
New antibiotic-resistant bacterial variants are emerging and spreading across France, raising global health concerns
What Are These New Variants
The study focused on a group of enzymes known as OXA-48-like carbapenemases, which enable bacteria to break down carbapenem antibiotics - often considered a last line of defense. Since 2022, scientists in France have identified five new variants named OXA-1181, OXA-1201, OXA-1205, OXA-1207, and OXA-1226.
These variants were mostly found in common bacteria such as Escherichia coli and Klebsiella pneumoniae, both of which can cause serious infections in humans. What makes this discovery concerning is not just the appearance of new variants, but how they are spreading and evolving.
How Widespread Is the Problem
Between 2022 and mid-2025, researchers analyzed 50 bacterial samples carrying these new variants. The majority were E. coli, often linked to high-risk clones known for spreading quickly. These bacteria were found in different parts of France and in various types of samples, including rectal swabs, urine, and even blood infections.
Interestingly, a significant number of cases were linked to international travel, particularly from regions such as Africa and Asia. This suggests that the spread of these resistant bacteria is not limited to one country but is part of a broader global movement.
A Key Mutation with Unknown Impact
One of the most intriguing findings was a shared mutation called S244W found in three of the new variants. This mutation occurs in a critical part of the enzyme that interacts with antibiotics.
Surprisingly, laboratory testing showed that this mutation did not significantly change how the bacteria responded to certain antibiotics. However, scientists believe its repeated appearance across different variants suggests it may still play an important role in how these enzymes evolve and adapt.
Why These Bacteria Are Hard to Treat
The real danger lies in the fact that these bacteria often carry multiple resistance mechanisms at the same time. Many of the samples studied also produced other enzymes such as NDM-5 and CTX-M-15, which further increase resistance.
As a result, these bacteria were resistant to several commonly used antibiotics, including advanced cephalosporins. While some newer drug combinations remain effective, reduced sensitivity was already observed in certain cases, raising concerns about future treatment options.
How They Spread So Easily
Another key finding is that the genes responsible for these enzymes are carried on plasmids - small
pieces of DNA that can easily move between bacteria. This allows resistance traits to spread rapidly, even across different bacterial species.
The study also revealed that these plasmids are highly similar to those seen in earlier variants, suggesting that bacteria are reusing successful genetic tools to survive and thrive.
Institutions Behind the Research
The research was conducted by teams from the Faculty of Medicine at Paris-Saclay University, INSERM, Bordeaux University Hospital, Université de Bordeaux and CNRS, the SEPSIS Comprehensive Center—IHU SEPSIS in Paris, the French National Reference Center for Antibiotic Resistance at Bicêtre Hospital, and Assistance Publique–Hôpitaux de Paris.
Why Continuous Monitoring Matters
This
Medical News report highlights the importance of ongoing surveillance. The steady rise in these variants, even if currently representing a small percentage, signals a dynamic and evolving threat. Scientists stress that early detection and monitoring are crucial to prevent wider outbreaks.
Conclusion
The emergence of these new OXA-48-like variants is a clear warning that antibiotic resistance continues to evolve in unpredictable ways. While some mutations may not immediately change how bacteria behave, their repeated appearance suggests deeper biological significance that scientists are only beginning to understand. The combination of multiple resistance mechanisms, global spread through travel, and easy gene transfer between bacteria creates a perfect storm for future healthcare challenges. Without strong surveillance systems and continued research into new treatments, these silent threats could escalate into major public health crises, making once-treatable infections far more dangerous and difficult to control.
The study findings were published in the peer reviewed journal: Microbiology Spectrum.
https://journals.asm.org/doi/10.1128/spectrum.00489-26
For the latest on drug resistant bacterial strains, keep on logging to Thailand
Medical News.
Read Also:
https://www.thailandmedical.news/news/uk-faces-surge-of-drug-resistant-super-fungus-called-trichophyton-indotineae
https://www.thailandmedical.news/news/are-covid-19-infections-triggering-the-emergence-of-drug-resistant-klebsiella-pneumoniae-strains-with-the-ndm-1-gene